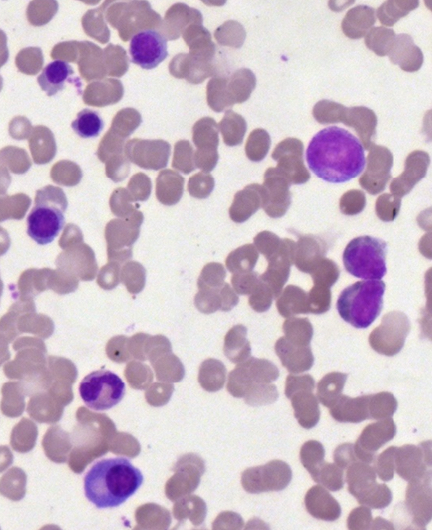

For almost two decades, we have provided prepared slides suitable for various biomedical courses. These glass slides contain sectioned, mounted, or smeared tissues stained with different methods.
They can be used to study histology, pathology, oral histology, oral pathology, embryology, microbiology, parasitology, and hematology.
Click the following categories to view example photos taken from these prepared slides.
Histology Slides
Pathology Slides
Oral Histology Slides
Oral Pathology Slides
Embryology Slides
Microbiology Slides
Parasitology Slides
Hematology Slides
The representative photos shown in each category are examples taken under the light microscope. They may not be the same ones as those available for your need. Complete lists of prepared slides for each course can be downloaded for further consideration.